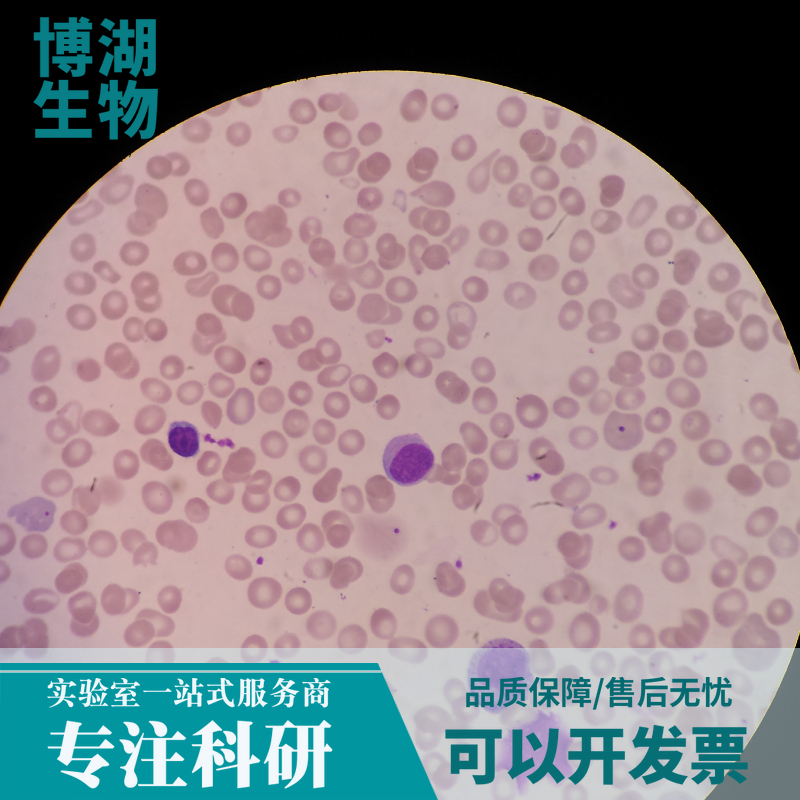
小鼠骨骼肌成纤维细胞

网站主页
小鼠骨骼肌成纤维细胞
小鼠骨骼肌成纤维细胞
小鼠骨骼肌成纤维细胞 新品
Mouse Skeletal Muscle Fibroblast Cells
¥3300
25T
起订
上海 更新日期:2026-04-17
产品详情:
- 中文名称:
- 小鼠骨骼肌成纤维细胞
- 英文名称:
- Mouse Skeletal Muscle Fibroblast Cells
- 品牌:
- 博湖
- 产地:
- 国产
- 保存条件:
- -20℃避光保存
- 产品类别:
- 原代细胞 小鼠原代细胞
- 种属:
- 小鼠
- 组织:
- 骨骼肌组织
- 细胞系:
- 小鼠原代细胞
- 细胞形态:
- 成纤维细胞样
- 生长状态:
- 贴壁
公司简介
派瑞曼pyram?是上海博湖生物科技有限公司(Shanghai Bohu Biological Technology Co., Ltd.,China)的产品品牌。
派瑞曼pyram?是一家化学、生化和材料科学等领域的科研用研发产品的制造商和供应商,我们的产品在相当宽的基础科学领域得到广泛的应用。 客户包括学术界、工业界和政府的研究和开发实验室以及制药、生物技术、化工/石化行业等具商业规模的企业。
派瑞曼pyram?除包括化学、分析化学、生命科学、材料科学和病理科学产品。质量是所有产品和服务最关键的组成部分,我们通过质量和实力赢得客户的信赖。产品的质量是企业的生命。
公司秉承"专注品质、诚信为本、服务至上、合作共赢"的企业文化积极参与生物领域的技术创新和技术服务,力求为我国科研事业更好的,更专业的服务!
| 成立日期 | (13年) |
| 注册资本 | 50.000000万人民币 |
| 员工人数 | 10-50人 |
| 年营业额 | ¥ 300万-500万 |
| 经营模式 | 贸易 |
| 主营行业 | 生物化工,细胞培养,分子生物学,细胞生物学 |
小鼠骨骼肌成纤维细胞相关厂家报价
-

- 小鼠骨骼肌成纤维细胞
- 上海康朗生物科技有限公司 VIP
- 2026-04-17
- ¥3300
-

- 小鼠骨骼肌成纤维细胞
- 上海抚生实业有限公司 VIP
- 2026-04-17
- ¥3300
-

- 小鼠骨骼肌成纤维细胞
- 上海西格生物科技有限公司 VIP
- 2026-04-17
- ¥3300
-

- 兔骨骼肌成纤维细胞
- 上海康朗生物科技有限公司 VIP
- 2026-04-17
- ¥3750
-

- 兔骨骼肌成纤维细胞
- 上海抚生实业有限公司 VIP
- 2026-04-17
- ¥3750